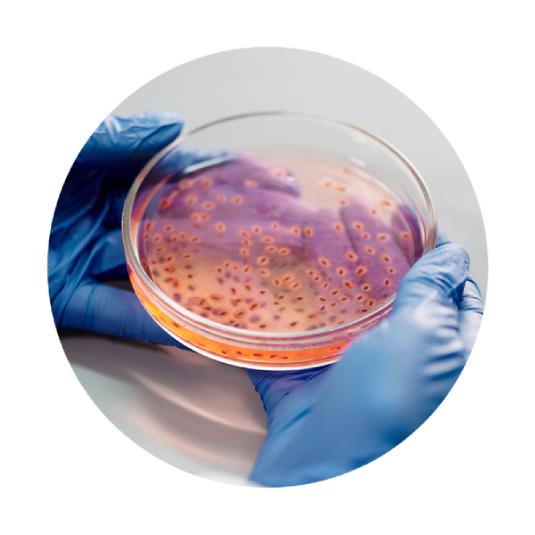

Recombinant proprietary conotoxin
Obtaining the expression of the gene encoding a myorelaxant conotoxin in the bacterial strain E.coli .
Our proprietary active substance - recombinant conotoxin, is obtained from E. coli bacterial strains. The conotoxin we obtain is identical to that originally produced by sea snails of the genus Conus .
Recombinant conotoxin is created as a fusion protein from recombinant genes, i.e. DNA molecules - deoxyribonucleic acid, which is the most common carrier of genetic information. Gene expression in bacterial cells is possible thanks to the use of special expression vectors with a strong promoter enabling the production of large amounts of protein in the recipient cell.

Expression imaging of the gene encoding a recombinant conotoxin
We use the gel electrophoresis technique to separate DNA fragments obtained in our laboratory based on their size and charge .
DNA molecules have a negative charge on their surface, so under the influence of an applied current they move in the agarose or polyacrylamide gel towards the positive electrode. To identify the size of DNA molecules, a mass standard is placed on the gel, which migrates in the gel in parallel with the analyzed sample and allows us to determine whether the desired product has been obtained.
By comparing the bands from the tested sample with the standard bands, we are able to determine the size of DNA molecules in the tested sample. The agarose gels with electrophoretically separated DNA fragments obtained in our laboratory are made visible thanks to a dye that binds to deoxyribonucleic acid and then glows under the influence of UV light.
Culture of an E. coli strain expressing a recomminant conotoxin
After obtaining the expression of the gene encoding the conotoxin, the breeding conditions of the host strain producing our active substance are selected. Both eukaryotic and prokaryotic expression systems are used to overproduce recombinant proteins.

Purification of recombinant conotoxin by affinity chromatography
The presence of recombinant conotoxin in cultures is confirmed on protein gels by SDS-PAGE electrophoresis, then the active substance of our cosmeceutical is purified using affinity chromatography methods. The peptide purification process is multi-stage, so we can be sure that we are getting rid of all bacterial contamination. The next step is to select the dialysis conditions in order to obtain a correctly folded peptide that has three disulfide bridges stabilizing its structure.

Confirmation of the activity of the author's recombinant conotoxin on oocyte cells
The final stage of production of the active ingredient of the Miorelaxant Magic cosmeceutical is the in vitro determination of the activity of the recombinant conotoxin and the introduction into a cream formulation that ensures the stability and activity of the conotoxin, guaranteeing its effectiveness. We confirm the conotoxin activity test using the patch-clamp method on live oocyte cell lines that overexpress human sodium channels specific for conotoxins. This study confirmed the myorelaxant activity of the recombinant conotoxin we obtained.
BEFORE AND AFTER
Results of application tests after 28 days of using Miorelaxant Magic cream twice a day by a group of 60 volunteers.
-
Button label
Reduction and smoothing of facial wrinkles around the eyes
-
Button label
Smoothing of nasolabial folds
-
Button label
The effect of lifting the upper eyelid
Check the results after 28 days:
-
Improved skin condition:
Button label
Good hydration: 80%
Increased skin softness: 71%
Increased skin tension: 71%
Increased skin brightness: 58%
Reduction of the visibility of wrinkles: 42%
Uniform color: 42%
Reduction of the visibility of pores: 42%
Reduction of sebum secretion: 47% -
Reduced and shortened wrinkles
Button label
Reduced wrinkle depth: 42%
Reduced wrinkle length: 36%
Reduced number of wrinkles: 32%
Suitable consistency: 95%
Adequate absorption: 87%
Suitable color: 96%
Ease of application: 93%
Noticeable difference in skin condition: 65% -
Product safety test reports
Button label